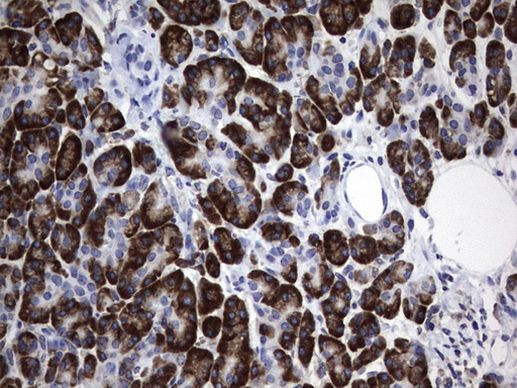
DDOST Antibody in Immunohistochemistry (Paraffin) (IHC (P))

Search
OriGene
DDOST Monoclonal Antibody (OTI2H2), TrueMAB™
{{$productOrderCtrl.translations['antibody.pdp.commerceCard.promotion.promotions']}}
{{$productOrderCtrl.translations['antibody.pdp.commerceCard.promotion.viewpromo']}}
{{$productOrderCtrl.translations['antibody.pdp.commerceCard.promotion.promocode']}}: {{promo.promoCode}} {{promo.promoTitle}} {{promo.promoDescription}}. {{$productOrderCtrl.translations['antibody.pdp.commerceCard.promotion.learnmore']}}
产品信息
TA803618
种属反应
宿主/亚型
分类
类型
克隆号
抗原
偶联物
形式
浓度
纯化类型
保存液
内含物
保存条件
运输条件
靶标信息
This gene encodes a component of the oligosaccharyltransferase complex which catalyzes the transfer of high-mannose oligosaccharides to asparagine residues on nascent polypeptides in the lumen of the rough endoplasmic reticulum. The protein complex co-purifies with ribosomes. The product of this gene is also implicated in the processing of advanced glycation end products (AGEs), which form from non-enzymatic reactions between sugars and proteins or lipids and are associated with aging and hyperglycemia.
仅用于科研。不用于诊断过程。未经明确授权不得转售。
篇参考文献 (0)
生物信息学
蛋白别名: advanced glycation end-product receptor 1; advanced glycation endproduct receptor 1; AGE-R1; DDOST 48 kDa subunit; Dolichyl-diphosphooligosaccharide--protein glycosyltransferase 48 kDa subunit; dolichyl-diphosphooligosaccharide--protein glycosyltransferase subunit (non-catalytic); dolichyl-diphosphooligosaccharide-protein glycotransferase; MGC2191; oligosaccharyl transferase 48 kDa subunit; oligosaccharyltransferase 48 kDa subunit; oligosaccharyltransferase subunit 48
基因别名: AGER1; CDG1R; DDOST; KIAA0115; OK/SW-cl.45; OKSWcl45; OST; OST48; WBP1
UniProt ID: (Human) P39656
Entrez Gene ID: (Human) 1650